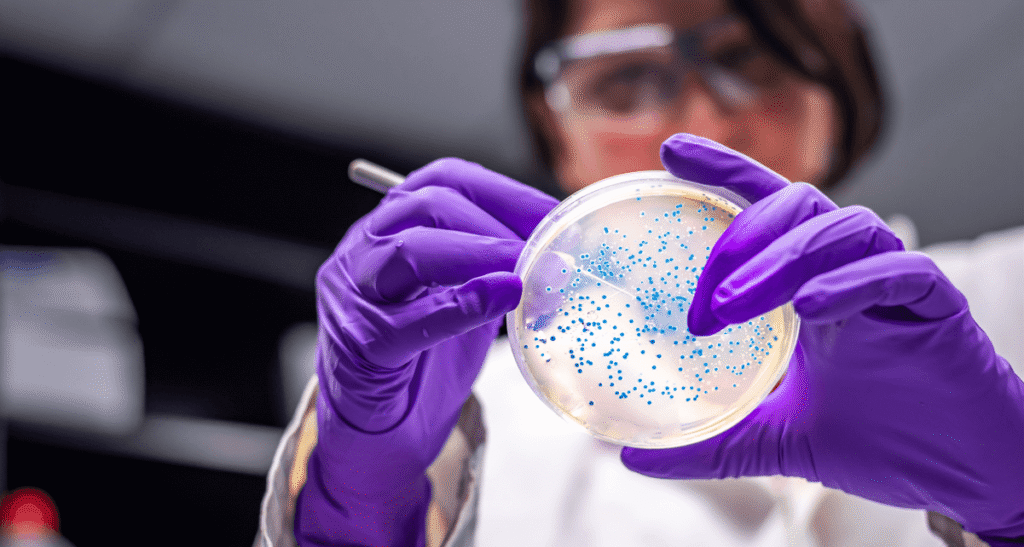

AI in Clinical Decision-Making: Hype vs. Reality

Artificial intelligence (AI) has rapidly become one of the most discussed technologies in healthcare, promising to revolutionize how decisions are made across clinical settings. From diagnostic support and imaging interpretation to risk prediction and workflow optimization, AI tools are being integrated into daily practice at an unprecedented pace. Yet, with the excitement comes a necessary […]
Precision Nutrition: Tailoring Diets Based on Genetic and Microbiome Profiles

In recent years, precision nutrition has emerged as a transformative approach within the broader field of personalized medicine. It represents a shift away from generic dietary guidelines toward a more individualized model that considers a person’s genetic blueprint, gut microbiome composition, lifestyle, metabolic biomarkers, and health goals. The rationale is simple but profound: each individual […]
tPCS Enhances Social and Sleep Function in Children With Autism

This multicenter, sham-controlled randomized clini- cal trial evaluated the safety and efficacy of prefron- tal-cerebellar transcranial pulsed current stimulation (tPCS) in improving social functioning and sleep in children with autism spectrum disorder (ASD). Conducted across participating centers in China, the study enrolled 312 children aged 3 to 14 years, who were randomly assigned to receive […]
Testosterone Therapy and Outcomes in Cirrhotic Hypogonadal Men

This study aimed to evaluate the impact of testosterone replacement therapy (TRT) on clinical outcomes in older men with cirrhosis and hypogonadism, a population frequently characterized by sarcopenia, anemia, and frailty. Using a target trial emulation design, investigators analyzed Medicare data (2008– 2020) to compare outcomes in 282 TRT users and 3517 non-users. A new-user […]
Medico-Metaverse: How Virtual Clinics Are Monetizing Attention, Not Just Care

For decades, the healthcare transaction was relatively straightforward. A patient walked into a clinic, described symptoms, received care, and left with a prescription or plan. But in 2025, the rules of engagement are rapidly changing. A parallel universe is taking shape—one where patients no longer just visit clinics, they enter experiences. Welcome to the medico-metaverse: […]
Chrono-Nutrition for Physicians

The human body doesn’t just function—it performs, on a meticulously timed stage governed by circadian rhythms. Deep within our organs, from the brain to the gut, lie biological clocks dictating when hormones should peak, when digestion should occur, and when rest should truly restore. For most people, this system hums quietly in the background. But […]
Rheumatoid Arthritis Flares May Contribute to Alzheimer’s Risk

Flares in rheumatoid arthritis (RA) may increase long-term risk of Alzheimer’s disease and related dementias (AD/ADRD), according to a cohort study published in the Scandinavian Journal of Rheumatology. Researchers analyzed 774 adults aged 50 or older with newly diagnosed RA and no prior cognitive impairment. Over a median 7.8-year follow-up, 79 patients (10%) developed AD/ADRD. […]
CagriSema Shows Impressive Weight Loss in Obese Adults With or Without Type 2 Diabetes

Once-weekly CagriSema—a combination of semaglutide and cagrilintide—has demonstrated significant weight reduction in adults with obesity, regardless of type 2 diabetes (T2D) status. Findings from the phase 3 REDEFINE 1 and REDEFINE 2 trials were presented at the American Diabetes Association’s 85th Scientific Sessions in Chicago, June 2025. REDEFINE 1 enrolled 3400 adults with obesity and […]
Microbiome Therapeutics: The New Frontier of Precision Medicine
Once relegated to the margins of medical science, the human microbiome has come to the forefront of modern therapeutics. This vast collection of microbes, bacteria, viruses, fungi, and their byproducts coexists with us, forming intricate relationships with nearly every physiological system. Technological advances in metagenomics and synthetic biology have enabled a granular understanding of these […]
Unlocking Access: The Global Challenge of Biologics in Clinical Practice

In the last two decades, biologic therapies have redefined treatment standards across a spectrum of chronic and life-threatening conditions. From autoimmune diseases and cancers to rare genetic disorders, these targeted therapies have given hope where traditional pharmacology often fell short. Their emergence represents the pinnacle of medical innovation, combining precision, efficacy, and personalized potential, all […]